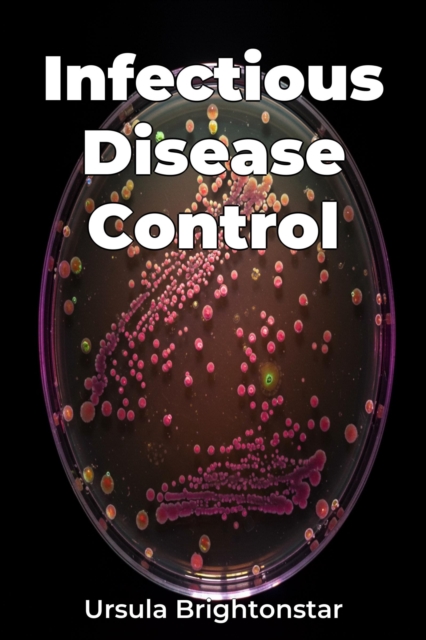
Infectious Disease Control

Infectious Disease Control
"Infectious Disease Control" tackles the urgent issue of managing infectious diseases in an era of rising antimicrobial resistance and emerging pathogens. The book underscores the critical role of public health interventions, epidemiology, and microbiology in combating disease transmission. Highlighting the historical context, it traces the evolution of control measures from sanitation to vaccines...
"Infectious Disease Control" tackles the urgent issue of managing infectious diseases in an era of rising antimicrobial resistance and emerging pathogens. The book underscores the critical role of public health interventions, epidemiology, and microbiology in combating disease transmission. Highlighting the historical context, it traces the evolution of control measures from sanitation to vaccines...
